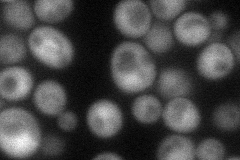
YDR196C
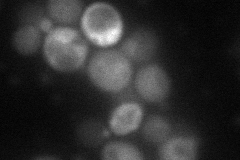
YDR196C
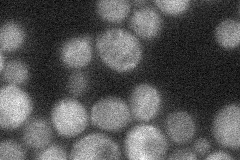
YDR196C
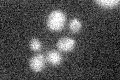
YDR196C

View description
Probable dephospho-CoA kinase (DPCK) that catalyzes the last step in coenzyme A biosynthesis; null mutant lethality is complemented by E. coli coaE (encoding DPCK); detected in purified mitochondria in high-throughput studies
Localization:
Intensity:
Fold change:
Significance:
-
C’ GFP library in SD

below threshold15.87 -
N' NOP1pr-GFP in SD
cytosol60.4922 -
N' TEF2pr-mCherry in SD
cytosol43.1857 -
N' NATIVEpr-GFP in SD
below threshold23.4291 -
N' TEF2pr-VC and Cyto-VN in SD

below threshold26.6363 -
C’ GFP library in SD+DTT

cytosol17.531.1No -
C’ GFP library in SD+H2O2

cytosol14.140.89No -
C’ GFP library in Starvation Media
cytosol16.561.04No -
C’ GFP library on the background of Pup2-DaMP

below threshold -
C’ GFP library on the background of CCT mutant

below threshold17.38851.09478No
